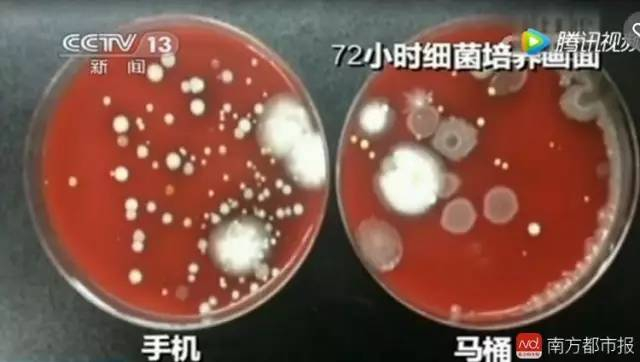

手机真比马桶水还脏?有人抽了自家马桶水去鉴定……
每日经济新闻

来源:南方都市报(微信号:nddaily)
每日经济新闻经授权转载
2012年的一篇外媒报道:
美国印第安纳州曼西市的实验室“HMLLabs”对手机细菌进行了一项测试。结果显示,从芝加哥某办公室里随机抽选出来的8部手机,全部带有大量大肠菌群,其数量之多已超过正常范畴。
这意味着手机受到了排泄物污染。这8部手机上的大肠菌群数量约在2700个到4200个单位之间。而根据饮用水标准,每100毫升饮用水的大肠菌群数量不能超过一个单位。(注:国内饮水相关标准是,每100毫升饮用水不能检出大肠菌群)“HMLLabs”实验室主任、波尔州立大学医学教授唐纳德•亨德里克森说:“这个结果相当糟糕。”他指出,这样的结果意味着手洗得不够勤,以及缺少适当的卫生措施。

2015年央视的生活实验室栏目一期名为“手机真的很脏吗?”的节目,取样检测了数部手机上的菌落情况。在节目中,实验人员随机对街头的被采访对象的手机进行取样,其中包括出租车司机的手机、小朋友玩的手机以及经常对手机进行擦拭的人士。
结果发现,取样的手机细菌经过培养,在培养皿中均长出了面积不小的菌落。与此同时,节目组还对ATM机按键、电梯按键、冲水马桶按键上的细菌也进行了取样,结论显示都优于手机。

手机真的有这么脏吗?5月5日,南都鉴定(微信公众号:nddaily)走进位于中科院广州化学所的广州中科检测技术服务有限公司,和专业人士一起对手机的卫生情况来一次专业检测。
时间:5月5日
地点:广州中科检测技术服务有限公司
测试对象:十部随机征集的手机、随机收取的门把手、2个不同马桶的马桶水
仪器:烧杯、试管、棉签、酒精灯、生理盐水、生物安全柜、培养皿、培养基、移液管、生化培养箱
目的:检测日常使用的手机,是否真的比马桶水、门把手更脏
标准:GB5749-2006生活饮用水卫生标准

取样

在这次试验中,我们随机抽取了十台志愿者的手机进行实验。这十台手机中最长是使用了4年时间,最短使用一年时间,其中,不少手机每天的使用频率都极高,基本“机不离手”的状态。

覃女士是中科检测的工作人员,她的手机已经使用时间是2年左右,“因为工作的关系,我们知道所有的物品上面都会有微生物菌的存在,但手机上的细菌究竟会有多少,我们也没有掌握过。
和覃女士在一个办公室的杨先生,手机使用时间有一年半了,平时空闲的时候都习惯于刷手机。他自言自己平时很注意卫生,注意到手机脏了,就会用纸巾擦干净。
另外,鉴定君还提供了三部手机,其中有一部手机闲置时间超过一年半,两部手机使用时间均超过一年。还有一部手机样品,由暨南大学一名学生志愿者提供。其他手机样品,均由中科检测实验室检测人员提供。

本次试验的目的是“手机会不会比马桶水更脏”,所以,另一对比物还需要马桶水。为了取到进行参照对比的鉴定样品,鉴定君也是拼了,自带家中的马桶水到检测机构进行测试。而且,为了参照样品的结果更严谨,鉴定组分别从两个家庭提取了马桶水进行检测。

除了马桶水之外,此次试验还选择了门把手作为手机细菌多少的另一参照物。“门把手人来人往,都会握,接触的细菌数次数和机会都很多,脏的程度也不可小觑。”工程师带着鉴定组,特意选择了办公室门把手以及人员流动比较密集的接待室门把手分别进行取样。“这两个地方接触的人比较多,办公室的门更是所有人每天都要握的。”负责实验的林工程师表示。

细菌培养

准备定量灭过菌的生理盐水,浓度为0.85%,盛于试管中。用生理盐水将棉签蘸湿之后,涂抹一遍手机的上下表面、四周等六个表面,最后将棉签把手部分折断,把有棉絮的一半投入之前的生理盐水试管中。

因为样品中的细菌数量庞大,难以计数,需要对样品原液进行稀释,再按照比例,计算出原样品中到底包含多少细菌。“我们主要检测的是大肠菌群和菌落总数两个数据。”中科检测分析测试中心高级工程师钟瑜表示,这两个也属于国家规定需要检测的饮用水水质常规检测指标。“大肠菌群是肠道致病菌一个比较典型的代表,数量多到一定程度,也意味着引起腹泻等疾病症状的几率会越高。”


样品的稀释过程需在无菌环境下进行。实验人员首先用酒精棉将实验室的生物安全柜操作台面擦拭一遍。之后,将样品放到完全无菌的生物安全柜上。生物安全柜温度保持在25℃左右,湿度保持在58%,内部的循环风保证柜内的环境一直无菌。


稀释之后的样品被放入培养皿中,再倒入结晶紫中性红胆盐培养基。固体样品需要处理后,变为液体才可进行检测。马桶水本身就是液体,可以直接拿移液管吸取滴入培养皿倒入培养基观察。马桶水同样也稀释两次。所有的样品都稀释完毕,并倒入培养基后,需静置十几分钟,待培养基凝固后再进行培养。“将培养皿倒置,不再有液体流出便算凝固成功。”钟瑜表示。之后,将全部培养皿放入37℃恒温的生化培养箱48小时,等待结果。

结果出炉

手机究竟会不会比马桶水脏?根据南都鉴定的结果,10部随机征集的手机,没有一部检测出含有大肠杆菌。两个门把手提取的样品中也不含大肠杆菌,鉴定组提供的两个马桶水样品中检测出大肠菌群,分别是62CFU/100mL和34CFU/100mL。
而另一测量指数菌落总数方面,根据国家出台的生活饮用水卫生标准(GB5749-2006),饮用水的菌落总数指标限值为100CFU/mL,饮用水的大肠菌群标准为0CFU/mL。以此标准,10部手机中,有实验人员提供的2部手机菌落总数超标,其中6号手机样品超标最多,超标5倍以上。两个门把手都没有超标。两个马桶水样品超标最多,分别达到了4.8X10的四次方CFU/mL和2.32X10的三次方CFU/mL。

鉴定结论
测试的是经常被清洁的手机还是没被清洁过的手机,是家用马桶与公共厕所的马桶,是马桶盖与马桶圈等等……这些因素都会影响检测的结果。本次检测初步考虑到被检测手机的清洁程度、使用者的卫生习惯,甚至手机不同位置的细菌数量不同等因素。
南都鉴定本次试验抽取的样本也只是很小的一部分,如果真的想用科学手段检测“手机和马桶谁更脏”,这将是一个工作量浩大的工程,将需要抽取更多的手机,更多的马桶水,进行更多种的对比试验。所以,通过这次试验,南都鉴定可以确定的是,单纯以“手机比马桶水还脏”作为一个确定的事实依据来宣传,有些夸大手机的卫生问题。
“细菌其实无处不在,我们生活的空间中时时刻刻都存在着各种细菌。”钟瑜表示,即便是检测出手机上有细菌,其实也没有必要恐慌。“最简单的例子,我们曾经检测过人的手,我们的手上每天都有10的3次方的菌落总数,但我们一样每天生活的很好。”钟瑜还表示,每个人对细菌的抵抗力不同,健康的人才不易生病。“所以,加强锻炼,注意卫生才是我们应该做的。”
鉴于现在人们和手机发生“亲密接触”的时间越来越长,钟瑜建议还是应该注意对自身手机的清洁工作。“手机每周消毒一次是有必要的。用75%的医用酒精或者市场上的消毒湿纸巾擦拭手机,即可达到清洁消毒的作用,非常方便。”
那么,手机可能传播疾病吗?公共卫生专家、广州市疾病预防控制中心传染病预防控制科科长李铁刚表示,我们所处的环境、水体,本身是有一定的细菌数量存在的,其中就包括了大肠杆菌和菌落总数。“国家往往会对它们的数量有一个明确的限制,超过了国家标准,才会致病或者有高致病风险,低于国家标准,则致病风险会降低。”
“此次检测10款手机发现,有部分手机的菌落总数超标,表明会有一定的传播腹泻、消化道疾病的风险。而菌落总数,往往是经培养后所有细菌的一个总称,它是一个很宽泛的概念。菌落总数致病,关键看这个菌落里的主流细菌是哪一种。假设菌落中是链球菌超标,那就可能导致链球菌感染的发生和传播风险提升,如果是大肠杆菌为主,那就是腹泻和消化道疾病传播风险提升。
李铁刚表示,细菌无处不在,但并不是有细菌就一定会传播疾病。这和细菌等病原体的浓度有关,也和潜在感染对象的个人体质、抵抗力强弱有关。“暴露在同样剂量的细菌下,不同的人群可能发生截然不同的反应。抵抗力低的会被感染,发病;抵抗力强的则不被感染,没事。还有一种人,他可能被感染了,但是不发病,成了一名隐性感染者,本身不发病,但却有了传播疾病的能力。”
要预防细菌传染性疾病,首先需要做的就是通过锻炼、健康作息、饮食来提升自己的抵抗力。而对于一些肠道传染病、接触性传染病的预防,关键就在于注意个人卫生,勤加洗手,不要随意将手伸进口中,也不要随意用手去擦拭眼睛。
每经编辑 李净翰

出品:南方都市报科学新闻工作室
主持/编辑:陈养凯
统筹:南都记者尹来
采写:南都记者尹来 王道斌 实习生王彤
摄影:南都记者 谭庆驹
其他用户正在看
1.“勒索病毒”太猖狂,迪士尼遭殃!黑客索要天价比特币,还放出狠话…
2.马云重回中国内地首富宝座!他还说了些大实话,句句扎心
3.一个66万亿的市场打开!刚刚,香港收到中央发来的超级礼包
4.中国80、90后住房拥有率冠绝全球,背后竟是因为丈母娘......